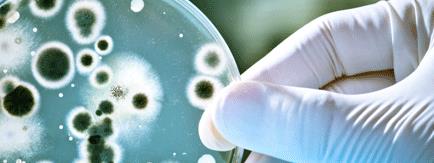

Una empresa lanza dos levaduras premium para vinos tintos, tras varios años de estudios
La empresa biotecnológica Guserbiot completa su gama Premium con dos nuevas levaduras para la elaboración de vinos tintos jóvenes y de guarda
Vitoria-Gasteiz
Lunes 08 de Julio de 2013
Leído › 7606 veces
En lugar de utilizar una levadura genérica para asegurar el correcto desarrollo de la fermentación alcohólica, esta vendimia, las bodegas españolas tendrán la oportunidad de elaborar sus vinos con dos nuevas levaduras premium, aisladas y seleccionadas por la empresa biotecnológica Guserbiot.
Estas dos nuevas levaduras, han sido aisladas a partir del hollejo de uvas tintas de viñedos españoles, después de varios años de estudios e investigaciones sobre la diversidad y ecología del género Saccharomyces en diferentes áreas vitivinícolas españolas. Las dos levaduras se caracterizan por respetar, desde el punto de vista aromático, el carácter varietal, además de presentar unas excelentes aptitudes enológicas para la elaboración de vinos con diferentes variedades de uva tinta. Su selección se ha realizado, además de tener en cuenta sus propiedades enológicas, en función del tipo de vino a elaborar, por lo que se tratan de levaduras especializadas para la elaboración de vinos tintos jóvenes y de guarda.
La levadura destinada a la elaboración de vino joven se ha utilizado para la producción de vinos con diferentes variedades de uvas tintas, entre ellas Bobal, Garnacha, Graciano, Mazuela, Mencia, Monastrell, Pinot Noir y Tempranillo. Es una levadura que proporciona vinos glicéricos, densos y redondos, con excelente cuerpo y estructura en boca. Su uso permite un mayor control sobre la fermentación, favoreciendo la expresión de notas típicas de frutos rojos.
La levadura para vino de guarda es una levadura testada en elaboraciones con variedades como: Bobal, Cabernet Sauvignon, Garnacha, Graciano, Malbec, Mazuela, Mencia, Merlot, Monastrel, Syrah y Tempranillo. Esta levadura se caracteriza por presentar una elevada capacidad autolítica, que favorece la estabilidad del color y reduce la astringencia, ofreciendo tras la guarda un vino equilibrado, con matices de frutos rojos y con intensidad media-alta de color, dependiente del tipo de uva.
Estas dos nuevas levaduras completan la gama de Levaduras Premium que ofrece la empresa alavesa para la elaboración de vino. Dentro de esta gama podemos encontrar dos levaduras autóctonas: Levadura autóctona de Rioja Alavesa y Levadura Autóctona de Rioja, lanzadas al mercado en anteriores vendimias.
"La buena respuesta que han tenido las levaduras autóctonas, nos has llevado a sacar al mercado dos variedades más para la elaboración de vino tinto", añade Sergio Gutiérrez, Presidente de Guserbiot.
Origen
Y es que hasta la fecha, la mayoría de las bodegas han recurrido a levaduras comerciales, procedentes de Francia y Australia, que si bien lograban evitar posibles alteraciones microbiológicas en las uvas, provocaban "una desnaturalización y estandarización de los aromas y sabores propios de los vinos nacionales".
Las Levaduras Premium de Guserbiot aportan un valor añadido a las bodegas, al tratarse de levaduras "no genéricas", aisladas y seleccionadas para la elaboración de diferentes vinos. "Entendíamos que el carácter autóctono y sobre todo, conocer el origen del aislamiento de las levaduras era sinónimo de seguridad para las bodegas", declara Sergio Gutiérrez.
Este compromiso y su carácter innovador llevó a la empresa Guserbiot a iniciar en 2004 un proyecto de investigación para aislar y seleccionar las levaduras más adecuadas para nuestros vinos.
El proyecto ha contado con la colaboración y el respaldo de importantes bodegas e entidades asociadas al mundo del vino, que mediante catas han testado y validado el producto en las distintas añadas en las que se ha aplicado.
El proceso de fermentación
Las levaduras del género Saccharomyces, son las responsables de la transformación del mosto mediante un proceso denominado fermentación alcohólica, que permite convertir un medio rico en azúcares en un medio cuyo principal componente es etanol. Durante la fermentación alcohólica, Saccharomyces cerevisiae produce numerosos aromas y sabores, siendo este proceso el responsable de que el producto final tenga un complejo perfil organoléptico. Además de la influencia en el aroma y sabor, las levaduras también tienen cierta influencia en el color del vino.
Desde un punto de vista microbiológico, las fermentaciones espontáneas, aunque naturales, son difíciles de controlar, ya que el mosto no es estéril, por lo que el proceso fermentativo puede verse afectado por la concentración y calidad de las cepas presentes, pudiendo resultar en desviaciones de la calidad organoléptica final del vino. Esta falta de control microbiológico y por lo tanto el riesgo de obtener un producto desviado, se subsanan con el uso de levaduras seleccionadas.
Guserbiot en su selección de levaduras sigue apostando por levaduras aisladas en nuestros viñedos, que respetan el carácter genuino de cada zona, a la vez que aseguran el proceso de vinificación y la calidad del vino.
| Más información |
|---|
| (PDF)Dossier Guserbiot |
Leído › 7606 veces
Tendencias
- Francia abre la convocatoria para el arranque definitivo de viñedos con una ayuda de 4.000 euros por hectárea
- El sector de vinos y espirituosos en EEUU apunta a la estabilidad tras un año de caídas
- La inteligencia artificial revoluciona la gestión del viñedo con predicciones de rendimiento superiores al 92%
- El Gobierno de España impulsa la internacionalización de la industria del vino con nuevos acuerdos comerciales y campañas de promoción
- El boicot y los aranceles hunden las importaciones de vino estadounidense en Canadá
- El Parlamento Europeo refuerza la protección y el apoyo a los productores de vino con una nueva legislación
- Italia reduce sus exportaciones de vino en 2025 ante la presión sobre precios y rentabilidad
- ProWein 2026 digitaliza el stand de prensa y elimina la presencia física de medios especializados
- El mar transforma el sabor de los vinos patagónicos según un panel de enólogos
- El sake japonés roza su récord de exportaciones en 2025 impulsado por el reconocimiento de la UNESCO
- Macron impulsa el arranque de viñedos no rentables para salvar la industria vinícola francesa
- El sector de bebidas alcohólicas de EEUU busca soluciones ante la incertidumbre y los nuevos hábitos de consumo
- La inteligencia artificial revoluciona la predicción de la fermentación del vino en los laboratorios españoles
- Wine Paris abre en un clima de incertidumbre mundial para el sector vinícola
- Italia refuerza su liderazgo en Wine Paris 2026 con récord de expositores y espacio en la feria
- La Fundación Osborne y la Universidad de Cádiz lanzan una titulación oficial para profesionales del enoturismo en Jerez